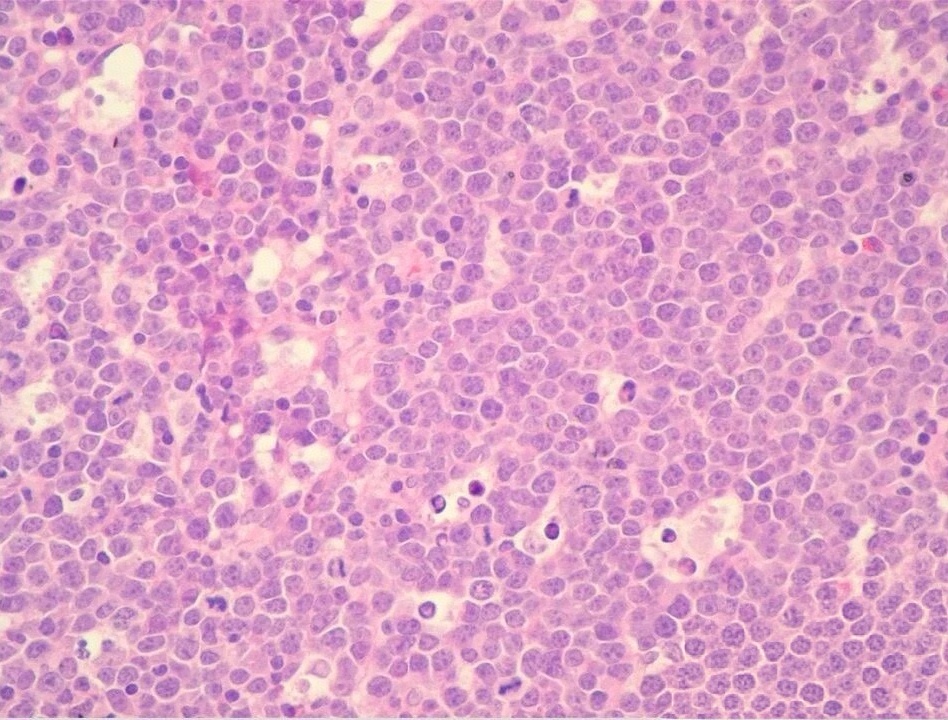
微信图片_20251206230848_61_2

正常淋巴结是人体免疫系统主要的组成部分之一,呈卵圆形或咖啡豆样外观,直径通常小于1cm,一般情况下在体表无法触及。常呈簇或串分布于身体各部位,主要位于肢体近端、颈部、纵隔、肠系膜、腹膜后、脾肺肾的门部和涎腺周边的血管周边。主要生物学功能是受抗原刺激后作为次级淋巴细胞器官负责淋巴细胞增生分化,以及淋巴液过滤和抗原呈递。
淋巴结切面呈灰粉色、质地软。主要结构分为皮质、副皮质和髓质。皮质位于淋巴结被膜下,由淋巴滤泡及其生发中心组成,代表B细胞区,与体液免疫相关。淋巴滤泡形态根据其活化状态而不同,初级滤泡由不活化的一致性小淋巴细胞组成圆形结节,直径约1mm;次级或反应淋巴滤泡由周围小B淋巴细胞构成的外套区和位于中央的生发中心组成。后者主要包含不同转化阶段的B淋巴细胞(小核裂和大核裂细胞称中心细胞,无核裂细胞称中心母细胞)、巨噬细胞和滤泡树突状细胞以及少数T淋巴细胞。其中中心母细胞组成生发中心暗区,朝向淋巴结中心,而中心细胞组成明区,朝向淋巴结外,外套区外层细胞胞浆略丰富,组成边缘区。副皮质区是滤泡间致密细胞区,代表胸腺依赖T细胞区,与细胞介导免疫反应有关。该区含不同大小,不同转化阶段的T淋巴细胞、毛细血管后微静脉(被覆高内皮细胞,管壁内有淋巴细胞),以及具有抗原呈递作用的指状突树突状细胞。髓质邻近门部,富含淋巴窦和动静脉,以及由淋巴细胞、成熟浆细胞、浆样淋巴细胞和浆母细胞组成的细胞索。
输入淋巴管穿过淋巴结被膜而开放于边缘窦,由此与结内错综复杂的淋巴窦网络相沟通,然后汇入输出淋巴管在门部出淋巴结。被覆在边缘窦外侧(即被膜下)的内皮细胞,与输人和输出淋巴管的内皮细胞相似,均属非吞噬细胞;而被覆在结内淋巴窦者却具有强烈的吞噬特性(即窦岸细胞或窦被覆组织细胞)。




图①:正常淋巴结 图②:箭头所指边缘窦图 ③:初级淋巴滤泡图 ④:次级淋巴滤泡
淋巴结肿大是身体免疫系统对异常情况(如感染、炎症、肿瘤等)的反应,处理需结合病因、症状严重程度分步骤应对,核心原则是“先明确原因,再针对性处理”,具体可按以下流程操作:
一、先初步判断:哪些情况可先观察,哪些需立即就医?
1. 可先居家观察的“良性情况”(多与感染/炎症相关)
若肿大淋巴结符合以下特点,多为普通感染(如感冒、口腔炎症、皮肤破损)引起的反应性增生,通常无需紧急处理:
①大小:直径<1厘米,质地偏软(类似鼻尖或嘴唇硬度);
②触感:表面光滑、能推动(不与皮肤或深层组织粘连);
③症状:可能有轻微压痛(按压时疼),无其他全身不适(如发烧、体重下降、乏力);
④伴随:近期有明确诱因(如牙疼、喉咙痛、感冒、皮肤红肿)。
居家观察要点:
① 记录变化:每天留意淋巴结大小、压痛是否减轻,避免反复按压刺激;
② 对症处理诱因:如牙疼治牙、喉咙痛用含片/淡盐水漱口、感冒对症吃感冒药,感染控制后,淋巴结通常1~2周内逐渐缩小;
③生活调整:多喝水、避免熬夜、清淡饮食,增强免疫力。
2. 必须立即就医的“危险信号”(需警惕肿瘤或严重疾病)
若出现以下情况,可能提示淋巴瘤、转移癌(如乳腺癌、肺癌转移)、结核或自身免疫病,需尽快到内科或血液科/肿瘤科就诊:
① 大小:直径>1厘米,或短期内(1~2周)明显增大;
② 触感:质地硬(类似额头硬度)、表面不光滑、固定不动(推不动);
③ 症状:无压痛(按压不疼),或伴随全身症状(如持续低烧、夜间盗汗、体重1个月内下降5%以上、乏力、皮肤瘙痒);
④ 其他:肿大超过2周不缩小,或同时出现多个部位淋巴结肿大(如颈部+腋窝+腹股沟同时肿)。
二、就医后:医生会做哪些检查明确病因?
不要自行猜测或拖延,医生会通过“问诊+检查”定位病因,常见检查包括:
1. 基础检查:
①触诊:用手触摸肿大淋巴结,判断大小、质地、活动度;
② 血常规:看是否有细菌/病毒感染(如白细胞升高提示细菌感染,淋巴细胞升高提示病毒感染)。
2. 针对性检查(根据怀疑病因选择):
①超声:最常用,判断淋巴结结构(良性多“皮髓质清晰”,恶性多“结构紊乱、无淋巴门”);
②穿刺活检:若怀疑恶性,需取少量淋巴结组织做病理检查(金标准,明确是否为肿瘤);
③ 其他:如结核菌素试验(怀疑结核时)、肿瘤标志物(怀疑转移癌时)、CT/MRI(看深部淋巴结或原发病灶)。
三、明确病因后:不同情况的治疗方案
1. 感染/炎症引起(最常见)
①细菌感染(如化脓性扁桃体炎、皮肤脓肿):医生开抗生素(如头孢、阿莫西林),按疗程吃,感染控制后淋巴结缩小;
②病毒感染(如感冒、EB病毒感染):无特效药,多靠自身免疫力恢复,可对症用退烧药、抗病毒药(如奥司他韦,仅流感有效);
③慢性炎症(如慢性咽炎、自身免疫病):治疗原发病(如用免疫抑制剂控制红斑狼疮),淋巴结可能长期轻微肿大,定期复查即可。
2. 结核引起(淋巴结结核)
需到感染科规范抗结核治疗,常用药物(异烟肼、利福平),疗程6~12个月,需严格遵医嘱服药,避免耐药。
3. 肿瘤相关(淋巴瘤或转移癌)
① 淋巴瘤:需血液科/肿瘤科治疗,根据类型(霍奇金/非霍奇金)选化疗、放疗、靶向药等;
②转移癌:先找原发病灶(如乳腺癌转移先治乳腺,肺癌转移先治肺),再结合手术、化疗、放疗控制转移灶。

图①:淋巴结结核 图②:淋巴瘤 图③:箭头所指转移癌
四、常见误区提醒
1. 别自行“消炎”:若不是细菌感染,吃抗生素无效,还可能导致耐药;
2. 别盲目热敷/按摩:热敷可能加重炎症,按摩可能刺激恶性淋巴结扩散;
3. 别因“不疼”忽视:恶性淋巴结多无压痛,反而“疼的淋巴结”更可能是良性感染。
总之,淋巴结肿大不能忽视,它不是“小病”也不是“绝症”,关键是及时区分良恶性、明确病因。若不能确定情况,尽快就医排查,宁早毋晚,避免因拖延错过最佳治疗时机。
重要提示:本文仅为健康知识科普,不构成任何医疗建议。具体诊断与治疗方案需由执业医生在全面评估后制定。若您有相关问题,请及时咨询专业医疗机构。